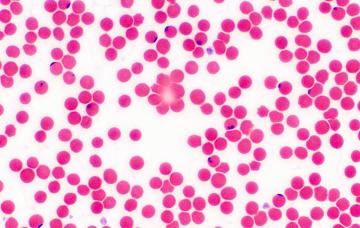

- 1

Qué es la enfermedad de Chagas
La enfermedad de Chagas es una grave parasitosis que causa la picadura de una chinche frecuente en América Latina, y que ya se ha extendido a España.
Leer más - 2

Transmisión de la enfermedad de Chagas
No todas las chinches están infestadas de tripanosoma. Pero si te muerde una chinche infestada, contraerás a buen seguro la enfermedad de Chagas.
Leer más - 3

Síntomas de la enfermedad de Chagas
La enfermedad de Chagas tiene síntomas como la lesión llamada chagoma, y puede causar conjuntivitis, ganglios inflamados y problemas cardíacos, entre otros.
Leer más - 4

Diagnóstico de la enfermedad de Chagas
El diagnóstico de la enfermedad de Chagas depende de la fase, como hacer frotis sanguíneo en la fase aguda, o la técnica ELISA en la fase crónica.
Leer más - 5

Tratamiento de la enfermedad de Chagas
Se usan dos tratamientos en la enfermedad de Chagas para curar la infección por tripanosoma, aunque debes conocer sus limitaciones y reacciones adversas.
Leer más - 6

Prevención de la enfermedad de Chagas
Para prevenir la infección causada por la enfermedad de Chagas, lo más efectivo es controlar la presencia de triatoma en las zonas endémicas con estas medidas.
Leer más
También te puede interesar...
Lo más leído esta semana
- 1
Padres quemados: impacto emocional de educar a un adolescente
- 2
Por qué es un temor infundado volver a coger peso tras un cáncer de mama
- 3
¿Podemos prevenir el TDAH? Intervenciones antes de los cinco años
- 4
Cuando el cerebro hace una pausa: así son las epilepsias de ausencia
- 5
Test ¿Eres una persona detallista?
- 6
Heridas familiares no resueltas: cómo sanar estos traumas
- 7
¿Los niños realmente necesitan suplementos vitamínicos?
- 8
Caries, ¿avanza o se detiene? Cómo evitar que despierten las lesiones inactivas
- 9
Periodontitis, prevención y tratamiento de esta afección bucodental
- 10
Resiliencia en casa: cómo ayudar a los niños a crecer fuertes día a día
Entrevista con el experto